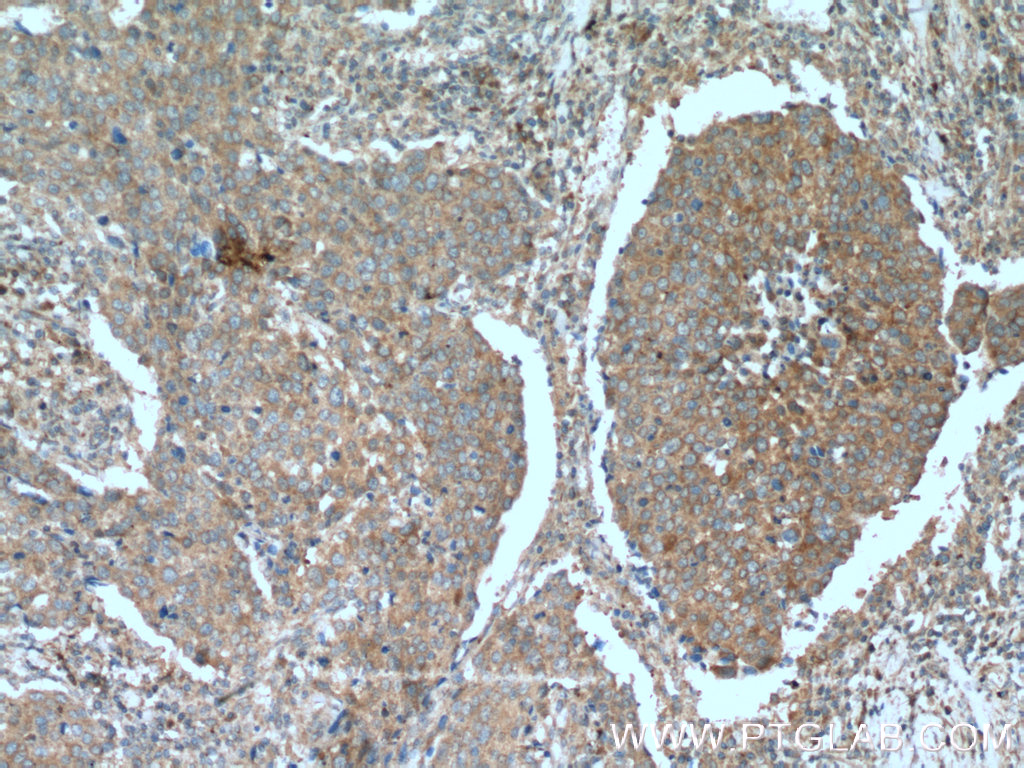

验证数据展示
经过测试的应用
| Positive WB detected in | human brain tissue, Jurkat cells |
| Positive IP detected in | mouse heart tissue |
| Positive IHC detected in | human lung cancer tissue, human breast cancer tissue Note: suggested antigen retrieval with TE buffer pH 9.0; (*) Alternatively, antigen retrieval may be performed with citrate buffer pH 6.0 |
| Positive IF/ICC detected in | MCF-7 cells |
推荐稀释比
| 应用 | 推荐稀释比 |
|---|---|
| Western Blot (WB) | WB : 1:500-1:3000 |
| Immunoprecipitation (IP) | IP : 0.5-4.0 ug for 1.0-3.0 mg of total protein lysate |
| Immunohistochemistry (IHC) | IHC : 1:100-1:400 |
| Immunofluorescence (IF)/ICC | IF/ICC : 1:50-1:500 |
| It is recommended that this reagent should be titrated in each testing system to obtain optimal results. | |
| Sample-dependent, Check data in validation data gallery. | |
产品信息
21890-1-AP targets PI3 Kinase p110 Alpha in WB, IHC, IF/ICC, IP, ELISA applications and shows reactivity with human, mouse, rat samples.
| 经测试应用 | WB, IP, IF, IHC, ELISA Application Description |
| 文献引用应用 | WB, IHC, IF |
| 经测试反应性 | human, mouse, rat |
| 文献引用反应性 | human, mouse, rat |
| 免疫原 | PI3 Kinase p110 Alpha fusion protein Ag16586 种属同源性预测 |
| 宿主/亚型 | Rabbit / IgG |
| 抗体类别 | Polyclonal |
| 产品类型 | Antibody |
| 全称 | phosphoinositide-3-kinase, catalytic, alpha polypeptide |
| 别名 | p110 alpha, PI3 Kinase p110 Alpha, PI3 kinase subunit alpha, PI3K, PI3K alpha, PI3K p110(alpha), PI3-kinase p110 subunit alpha, PIK3CA, PtdIns 3 kinase subunit alpha |
| 计算分子量 | 1068 aa, 124 kDa |
| 观测分子量 | 110 kDa |
| GenBank蛋白编号 | BC113601 |
| 基因名称 | PIK3CA |
| Gene ID (NCBI) | 5290 |
| 偶联类型 | Unconjugated |
| 形式 | Liquid |
| 纯化方式 | Antigen affinity purification |
| UNIPROT ID | P42336 |
| 储存缓冲液 | PBS with 0.02% sodium azide and 50% glycerol , pH 7.3 |
| 储存条件 | Store at -20°C. Stable for one year after shipment. Aliquoting is unnecessary for -20oC storage. |
背景介绍
PIK3CA belongs to the PI3/PI4-kinase family. It phosphorylates PtdIns, PtdIns4P and PtdIns(4,5)P2 with a preference for PtdIns(4,5)P2. Defects in PIK3CA are associated with colorectal cancer (CRC). Defects in PIK3CA are associated with breast cancer. Defects in PIK3CA are associated with ovarian cancer. Defects in PIK3CA may underlie hepatocellular carcinoma (HCC). Defects in PIK3CA are a cause of keratosis seborrheic (KERSEB).
实验方案
| Product Specific Protocols | |
|---|---|
| WB protocol for PI3 Kinase p110 Alpha antibody 21890-1-AP | Download protocol |
| IHC protocol for PI3 Kinase p110 Alpha antibody 21890-1-AP | Download protocol |
| IF protocol for PI3 Kinase p110 Alpha antibody 21890-1-AP | Download protocol |
| IP protocol for PI3 Kinase p110 Alpha antibody 21890-1-AP | Download protocol |
| Standard Protocols | |
|---|---|
| Click here to view our Standard Protocols |
发表文章
| Species | Application | Title |
|---|---|---|
Food Funct l-Theanine regulates glucose, lipid, and protein metabolism via insulin and AMP-activated protein kinase signaling pathways | ||
J Agric Food Chem β-Sitosterol-D-glucoside from sweet potato exerts an anti-breast cancer activity by upregulating microRNA-10a and PI3K/Akt signaling pathway. | ||
J Hematol Oncol Long non-coding RNA-SNHG7 acts as a target of miR-34a to increase GALNT7 level and regulate PI3K/Akt/mTOR pathway in colorectal cancer progression. | ||
Sci Rep NaoXinTong Capsules inhibit the development of diabetic nephropathy in db/db mice. | ||
J Exp Clin Cancer Res LINC01296/miR-26a/GALNT3 axis contributes to colorectal cancer progression by regulating O-glycosylated MUC1 via PI3K/AKT pathway. | ||
Sci Rep Hypoxia-induced ANGPTL4 sustains tumour growth and anoikis resistance through different mechanisms in scirrhous gastric cancer cell lines. |